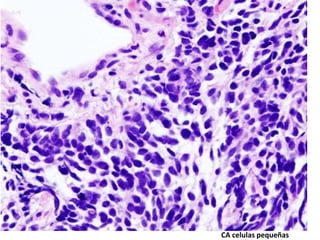
CA celulas pequeñas

Este documento resume la patología de los tumores pulmonares. Describe la epidemiología, factores de riesgo, clasificación e histología de los tumores pulmonares, con un enfoque en el cáncer de pulmón de células pequeñas. También discute los métodos de diagnóstico como la citología de esputo, broncoscopía y punción guiada por TAC, así como los procedimientos quirúrgicos y la estadificación del cáncer pulmonar.







![Clasificación:
• Resumen de la OMS 2004
histologico según Robbins:
• - Epidermoide
• - Adenocarcinoma
• - Ca celulas pequeñas
• - Ca celulas grandes
• -Ca.pleomorfico,sarcomatoide.
• -Ca. Adenoescamoso
• -Tumor carcinoide
• -Ca tipo glandular salival
• -Ca inclasificable
• Clinica:
• -Celulas microciticas (ca
celulas pequeñas, ca
neuroendocrino de celulas
grandes, ca carcinoide y
mixtos[con areas de no
microcitico])
• -Celulas no Microciticas.](https://image.slidesharecdn.com/cancerdepulmonclase2014-160831174928/85/Cancer-de-pulmon-clase-2014-8-320.jpg)